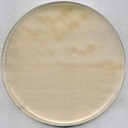
AGAR R2A PARA MICROBIOLOGIA. 500 GRAMOS. MARCA MERCK

AGAR R2A PARA MICROBIOLOGIA. 500 GRAMOS. MARCA MERCK
Propiedades
Agency: (US-EPA) EP
Nivel de calidad: 200
esterilidad: non-sterile
Formulario: granular
envase:
- pkg of 5 kg
- pkg of 500 g
fabricante / nombre comercial: GranuCult®
condiciones de almacenamiento: (Tightly closed. Dry.)
técnicas: microbiological culture: suitable
solubilidad: 18.2 g/L
aplicaciones:
- microbiology
- pharmaceutical
temp. de almacenamiento: 15-25°C
idoneidad: heterotrophic bacteria
Descripción general
El agar R2A es un medio de cultivo con un bajo contenido de nutrientes, que, en combinación con una baja temperatura de incubación y un tiempo de incubación prolongado, es adecuado para la recuperación de las bacterias sometidas a condiciones de estrés y tolerantes al cloro del agua potable. En la Farmacopea Europea (EP) 10.0, se describe el agar R2A para la supervisión microbiológica del recuento microbiano total en agua para el agua purificada a granel y para para inyectables a granel
Aplicación
El agar R2A es un medio nutritivo para la determinación del recuento total de bacterias heterótrofas en el agua potable.
Características y beneficios
Vida útil prolongada de hasta cinco años
Información legal
GRANUCULT is a registered trademark of Merck KGaA, Darmstadt, GermanyNutriSelect is a registered trademark of Merck KGaA, Darmstadt, Germany